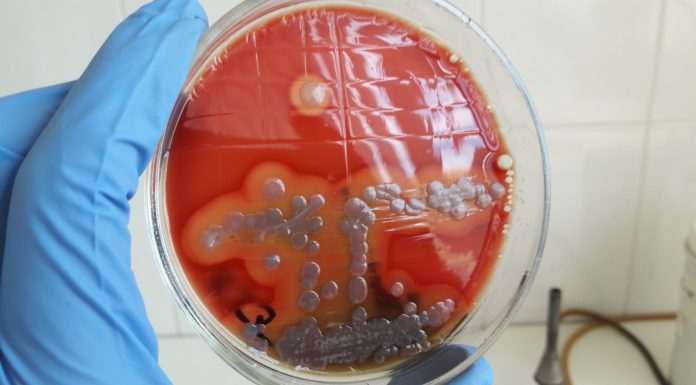
Какие инфекции показывает бак посев

Хирургическая стоматология: сложные случаи
Абсолютное здоровье полости рта - мечта многие люди. Однако не всегда удаётся избежать проблем со зубами и деснами. Некоторые требуют хирургического вмешательства.
Периодонтит
Воспалительный процесс, затрагивающий все ткани пародонта - десну, кость и соединительное вещество. В сложных случаях, когда заболевание прогрессирует, стоматолог может применить следующие методы лечения:
Корневая экстирпация - удаление поврежденной или некротической ткани из...
Для чего нужны модульные лаборатории
В современном мире, где научно-технический прогресс развивается во все более стремительном темпе, иметь доступ к современным и эффективным лабораториям является необходимостью.
Модульные лаборатории представляют собой инновационные сооружения, предназначенные для проведения широкого спектра исследований и экспериментов. Но для чего на самом деле нужны?
Во-первых, модульность - ключевое понятие, отличающее эти лаборатории от традиционных. Конструкция модульной лаборатории позволяет...
Почему слезятся глаза и что с этим делать
Слезы – это не только проявление эмоций, но и защитный механизм организма. Они помогают поддерживать влажность глаза и удалять различные раздражители. Однако, когда глаза начинают слезиться из-за различных факторов, это может вызывать дискомфорт и требует внимания. Многие люди интересуются, от чего слезятся глаза?
На первый взгляд может показаться, что слезы — это признак просто переизбытка...
Какие инфекции показывает бак посев
В мире, невидимом для невооруженного глаза, развертывается настоящая драма в микроскопических масштабах, где героями являются бактерии. И чтобы раскрыть этот биологический триллер, на помощь приходит метод – бак посев.
Путешествие в мир бактерий
Бактерии – разнообразные микроорганизмы, обитающие повсюду, от наших кожных покровов до далеких уголков природы. Некоторые из них – доброжелательные, оказывающие благотворное воздействие на...
Необходимость автоматического наружного дефибриллятора в стоматологии
Ежедневно бесчисленное множество людей посещают общественные места. Вероятность того, что у кого-то произойдет внезапная остановка сердца, угрожающе высока, причем это может случиться как со взрослыми, так и с детьми. За год у детей происходит около двух тысяч неожиданных остановок сердца, а у взрослых— около трехсот тысяч. Это явление не ограничивается больницами, оно происходит и в...
ЭТО ВАМ ПРИГОДИТСЯ
Для чего нужен сертификат психиатра?
Наличие психиатрического сертификата необходимо, чтобы решить личные и профессиональные проблемы. Она нужна, если устраиваются работать на определенные должности.
Сейчас не проблема получить сертификат психиатра (форма...
Сколько времени может длиться алкогольный запой?
Алкогольная зависимость является самым распространенным заболеванием нашего времени.
Данное заболевание не щадит никого, вне зависимости от их пола и возраста. Страдать алкогольной зависимостью могут даже...
Особенности применения лазерной эпиляции
Лазерную эпиляцию считают продвинутым методом. Он позволяет удалить лишнюю растительность. Его уровень популярности обусловливает безболезненность, высокий эффект. Лазерная эпиляция ног стала более доступной и...
Что такое гранола и чем она полезна?
Обычная овсянка и так любима и детьми, и взрослыми, а если на ее основе приготовить полезный продукт с добавлением орехов, сухофруктов и других ингредиентов,...
Препараты ME Line: уникальная разработка испанской компании, предназначеная для лечения всех типов пигментаци
Профессиональная косметика meline считается уникальной совершенно разработкой компании испанской Innoaesthetics, предназначением которой является лечении пигментаций всех абсолютно типов. Создателем данной системы является основатель компании,...
Родильный Дом Лелека: высокий уровень мировых стандартов
Каждая будущая мама еще на начальных сроках беременности задумывается о своей первой встрече с малышом. Это незабываемый момент, который откладывает радостный отпечаток в...